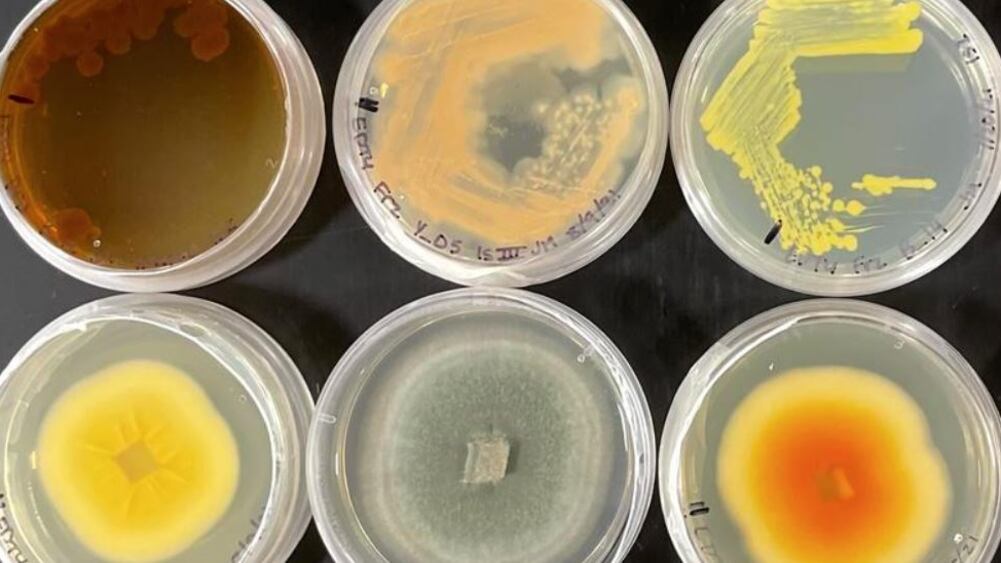

MADRID, 25 (EUROPA PRESS)
Hongos y bacterias capaces de sobrevivir a los megaincendios de los bosques de secoyas tanoak son «primos» microbianos que a menudo aumentan en abundancia después de sentir las llamas.
Es el hallazgo que científicos de la Universidad de California Riverside (UCR) presentan en una investigación publicada en la revista Molecular Ecology.
Los incendios de un tamaño e intensidad sin precedentes, llamados megaincendios, son cada vez más comunes. En el oeste de Estados Unidos, el cambio climático está provocando un aumento de las temperaturas y un derretimiento más temprano de la nieve, lo que prolonga la estación seca cuando los bosques son más vulnerables a la quema.
Aunque algunos ecosistemas están adaptados para incendios menos intensos, se sabe poco sobre cómo las plantas o sus microbiomas del suelo asociados responden a los megaincendios, particularmente en los carismáticos bosques de secoyas tanoak de California.
«No es probable que las plantas puedan recuperarse de los megaincendios sin hongos beneficiosos que suministren nutrientes a las raíces, o bacterias que transformen el carbono y el nitrógeno adicionales en el suelo después del incendio», dijo Sydney Glassman, micólogo de la UCR y autor principal del estudio. «Comprender los microbios es clave para cualquier esfuerzo de restauración».
Además de examinar los efectos de los megaincendios en los microbios del bosque de secoyas tanoak, el estudio es inusual por otra razón. Se tomaron muestras de suelo de las mismas parcelas antes e inmediatamente después del incendio de Soberanes de 2016 en el condado de Monterey.
«Para obtener este tipo de datos, un investigador casi tendría que quemar la trama por sí mismo. Es muy difícil predecir exactamente dónde se quemará», dijo Glassman en un comunicado.
El equipo no se sorprendió al descubrir que el incendio de Soberanes tuvo un impacto masivo en las comunidades de bacterias y hongos, con una disminución de hasta un 70 % en la cantidad de especies de microbios. Se sorprendieron de que algunas levaduras y bacterias no solo sobrevivieran al fuego sino que aumentaran en abundancia.
Las bacterias que aumentaron incluyeron actinobacterias, que son responsables de ayudar a que el material vegetal se descomponga. El equipo también encontró un aumento en Firmicutes, conocido por promover el crecimiento de las plantas, ayudar a controlar los patógenos de las plantas y remediar los metales pesados ??en el suelo.
En la categoría de hongos, el equipo encontró un aumento masivo en la levadura Basidioascus resistente al calor, que es capaz de degradar diferentes componentes de la madera, incluida la lignina, la parte resistente de las paredes celulares de las plantas que les da estructura y las protege de los ataques de insectos.
Algunos de los microbios pueden haber utilizado estrategias novedosas para aumentar su número en los suelos con cicatrices de quemaduras. «El penicillium probablemente se está aprovechando de los alimentos liberados de la necromasa, o ‘cadáveres’, y algunas especies también pueden comer carbón», dijo Glassman.
Quizás el hallazgo más significativo del equipo es que los hongos y las bacterias, tanto los que sobrevivieron al megaincendio como los que no, parecen estar relacionados genéticamente entre sí.
«Han compartido rasgos de adaptación que les permiten responder al fuego, y esto mejora nuestra capacidad de predecir qué microbios responderán, ya sea positiva o negativamente, a eventos como estos», dijo Glassman.
En general, se sabe poco sobre los hongos y el alcance total de sus efectos sobre el medio ambiente. Es imperativo que estudios como estos continúen revelando las formas en que pueden ayudar al medio ambiente a recuperarse de los incendios.
«Una de las razones por las que hay tan poca comprensión de los hongos es que hay muy pocos micólogos que los estudien», dijo Glassman. «Pero realmente tienen impactos importantes, especialmente después de los grandes incendios que solo aumentan en frecuencia y gravedad tanto aquí como en todo el mundo».